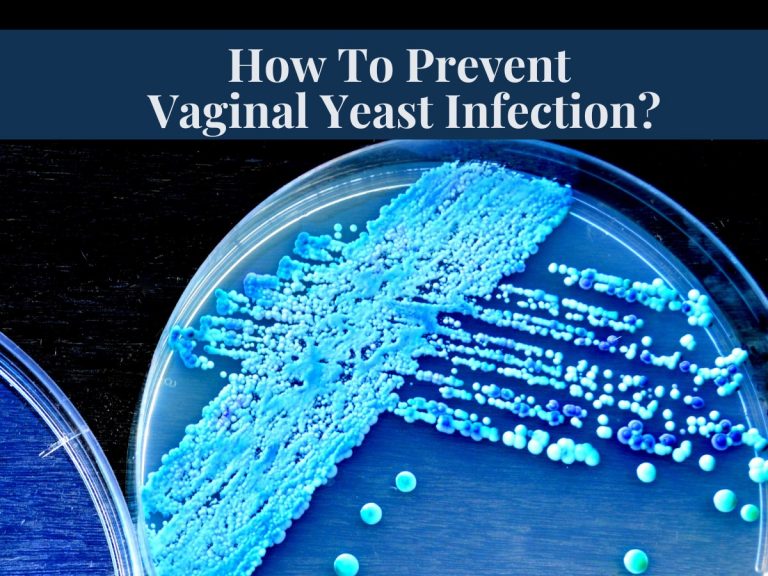

How To Prevent Vaginal Yeast Infections? Dietary And Lifestyle Modifications
Vaginal yeast infections, also known as Vulvovaginal Candidiasis, are caused by a common yeast specie, Candida albicans. According to several scientific...

Why Does Yeast Infection Medicine Burn? Reality And Reviews
Vaginal yeast Infections, also known as Candidiasis, are the most common infections women encounter worldwide. Candidiasis is caused by a...

Castor Oil Packs: Unleashing The Wonders Of An Ancient Panacea
You may be familiar with castor oil’s healing properties and have been using it for a long. But did you...

How Fast Can A Man Get A Yeast Infection From A Woman?
An overgrowth of yeast, particularly Candida albicans, can cause yeast infection. The infection can occur in the mouth, genitalia, and...

Yeast Infection Bleeding When Wiping Is That What I Heard?
You may all be familiar with a yeast infection, its common to rare symptoms, causes, preventions, and management. But not...

How To Prevent Yeast Infection After Sex? Sexual Wellness 101
Yeast infections can be oral, vaginal, and penile (Balanitis). They can spread from one partner to another in many ways,...




